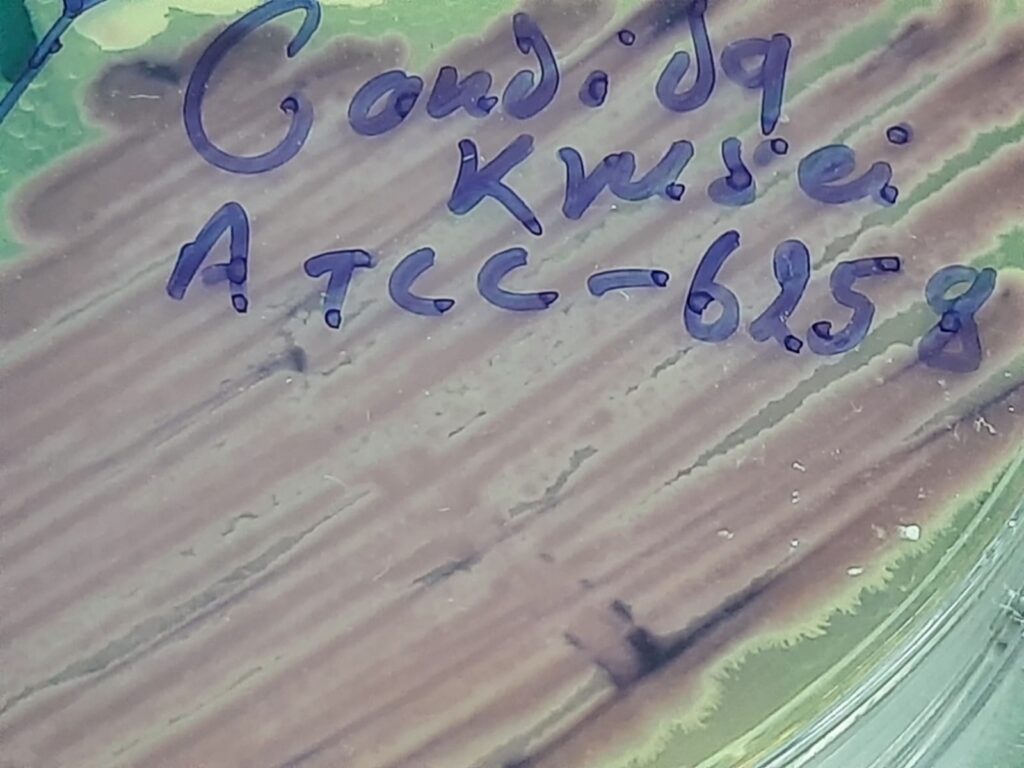
Pichia kudriavzevii ATCC strain on HiCrome Candida differential agar

Pichia kudriavzevii-Introduction, Morphology, Pathogenicity, Lab Diagnosis, Treatment, Prevention, and Keynotes
Introduction
Pichia kudriavzevii, formerly known as Candida krusei, is a unique budding yeast that holds a dual status as both a critical industrial organism and an emerging opportunistic pathogen. Taxonomy: It is the teleomorph (sexual state) of Candida krusei. It has also been historically known as Issatchenkia orientalis. ccurrence: It is ubiquitous in nature, found in soil, fruits, and fermented foods like chocolate and coffee. Industrial Importance: Used globally for bioethanol production due to its high tolerance to extreme heat (up to 45°C) and low pH (as low as 2.0).
Morphology
- Microscopic Appearance: Produces ovoid or elongated ellipsoidal budding cells, often described as having a “match-stick” or “long-grain rice” appearance.
- Culture Characteristics:
Pathogenicity
- Risk Factors: Primarily affects immunocompromised patients, such as those with neutropenia, hematological malignancies (leukemia), or those undergoing organ transplants.
- Virulence Factors: Includes the ability to form biofilms, produce degradative enzymes (phospholipases, proteases, hemolysins), and adhere to host tissues.
- Clinical Manifestations:
- Fungemia: Bloodstream infections associated with high mortality rates (up to 67%).
- Vaginitis: An important etiological agent in some cases of vaginal candidiasis.
- Other: Fungal peritonitis, endocarditis, and mucocutaneous infections.
Lab Diagnosis
- Culture: Isolation on Sabouraud Dextrose Agar (SDA) followed by observation of spreading matte colonies.
- Biochemical Tests: Distinguished by its ability to grow on vitamin-free media (unlike most Candida species) and its specific sugar fermentation profile (ferments glucose but typically not sucrose or lactose).
- Molecular Methods: Definitive identification via DNA sequencing of the ITS1-ITS2 or D1/D2 regions of rDNA.
- MALDI-TOF MS: Now a standard tool for rapid species-level identification in clinical labs.
Treatment
- Intrinsic Resistance: It is naturally resistant to fluconazole, a common antifungal. This is due to low affinity for the target enzyme and high expression of efflux pumps.
- Recommended Agents:
- Voriconazole: Often effective.
- Amphotericin B: Generally effective, though it may show reduced susceptibility compared to C. albicans.
- Echinocandins: Such as caspofungin, micafungin, and anidulafungin.
Prevention
- Infection Control: Strict hygiene and sanitation in healthcare settings, including handwashing and disinfecting medical equipment.
- Stewardship: Avoiding unnecessary prophylactic use of fluconazole, which can select for this resistant species.
- Surveillance: Monitoring the incidence and susceptibility patterns in hospital environments to prevent outbreaks.
Keynotes
- The “One-Name” Rule: Modern taxonomy prefers Pichia kudriavzevii over its asexual name, Candida krusei.
- WHO Priority: It is listed on the World Health Organization’s Fungal Priority Pathogen List due to its drug resistance and high mortality.
- Acid Specialist: Its unique ability to degrade organic acids (like lactic acid) makes it a “yeast of choice” for coffee and cocoa fermentation.
Further Readings
- https://www.sciencedirect.com/topics/agricultural-and-biological-sciences/pichia-kudriavzevii
- https://www.sciencedirect.com/topics/biochemistry-genetics-and-molecular-biology/pichia-kudriavzevii
- https://www.researchgate.net/publication/381771529_Pichia_kudriavzevii_Candida_krusei_A_systematic_review_to_inform_the_World_Health_Organisation_priority_list_of_fungal_pathogens
- https://edoc.rki.de/bitstream/handle/176904/13436/myad132.pdf?sequence=1&isAllowed=y
- https://en.wikipedia.org/wiki/Pichia_kudriavzevii
- https://www.mdpi.com/2309-608X/9/2/170
- https://academic.oup.com/mmy/article/62/6/myad132/7700351
- https://www.mdpi.com/2673-8007/5/1/30
- https://www.jaypeedigital.com/eReader/chapter/9788180616709/ch55
- https://medtigo.com/pathogen/pichia-kudriavzevii
[613 visitors]
